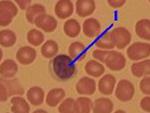
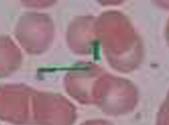

Агранулоциты. Лимфоциты
а) Общая харакеристика.
По размеру – малые (6–7 мкм), средние (8–9 мкм) и большие (12–15 мкм) лимфоциты.
| Морфо-логия | 1) В крови преобладают малые (80-85%) и средние (10%) лимфоциты. 2) У этих клеток - ядро – округлое, тёмное, - цитоплазма – в виде узкого базофильного (голубого) ободка без гранул. |
Рис. 8.6.
Лимфоцит
Мазок крови
Окраска
по Романовскому
Рис. 8.6.
Лимфоцит
Мазок крови
Окраска
по Романовскому
|
| Основные виды лимфоцитов | 1) Малые и средние лимфоциты по происхождению и функции делятся на В- (30%) и Т- (60-65%)-клетки. 2) Большие (гранулированные) лимфоциты – это NK-клетки (5-10%). | |
| Функция | Функция лимфоцитов – специфическое распознавание и уничтожение чужеродных для организма объектов. То и другое достигается в ходе иммунной реакции, которая может быть гуморальной или клеточной. |
б) В-лимфоциты
| Особен-ности | В-лимфоциты - образуются в большинстве своём в красном костном мозгу, - несут на поверхности рецепторные иммуноглобулины (BCR – В-клеточные рецепторы), специфичные к тому или иному антигену; - по специфичности этих BCR подразделяются на множество клонов и - являются основными участниками гуморальных иммунных реакций. |
| Суть реакций | Суть этих реакций – в том, что стимулированные антигенами В-лимфо-циты превращаются в плазматические клетки, которые продуцируют антитела, связывающие и обезвреживающие данные антигены. |
| Механизм гуморальных иммунных реакций | 1) Реакции вызываются бактериями и растворёнными макромолекулами. В-клетки тех или иных клонов узнают и связывают их своими BCR. Необходимо, чтобы антиген был узнан и вторым участником – Т-хелперами («помощниками») соответствующей специфичности. 2,а) Тогда в стимулированных В-клетках лимфоузлов, миндалин и т.п. начинаются сложные процессы – мутагенез генов Ig, отбор и размножение клеток с наилучшими результатами мутагенеза. 2,б) После этого - одни дочерние клетки сохраняются как В-клетки памяти, - а другие вступают в дифференцировку (в них сильно развиваются шероховатая ЭПС и аппарат Гольджи). 3,а) В результате дифференцировки образуются плазматическиеклетки. Синтезируемые ими антитела – это иммуноглобулины (Ig), близкие по своей специфичности к исходным BCR. 3,б) Поэтому они тоже связывают антигены, но уже – в свободной среде. |
в) Т-лимфоциты
| Виды | 1) Т-лимфоциты образуются втимусе. 2) Их множество составляют клетки с разной функцией, в т.ч. - Т-киллеры (клетки-«убийцы») – основные участники клеточных иммунных реакций - и Т-хелперы («помощники»), необходимые для протекания большинства как гуморальных, так и клеточных иммунных реакций. |
| TCR | 1) Те и другие несут на поверхности TCR (Т-клеточные рецепторы), более просто устроенные, нежели BCR,но тоже достаточно разнообразные. 2) С их помощью узнаётся не весь антиген (белок), а лишь та или иная антигенная детерминанта (АД) – пептид из 8–11 или 15–20 остатков аминокислот. |
| Суть клеточных иммунных реакций | 1) Клеточную иммунную реакцию вызывают эукариотические клетки, несущие на поверхности чужеродные АД: - собственные клетки организма, пораженные вирусом; - опухолевые клетки; клетки трансплантата. 2) Суть последующей реакции – в том, что активные Т-киллеры (образовавшиеся в результате размножения Т-киллера, стимулированного с помощью Т-хелперов и т.н. АПК – антигенпредставляющих клеток) - своими TCR узнают на поверхности клеток соответствующие АД, - связываются с ними и - разрушают клетки с помощью белка перфорина, который формирует в мембране «жертвы» гидрофильные поры. 3) Последние инициируют одновременно развитие и некроза (за счёт осмотического шока), и апоптоза в атакуемой клетке. |
8. Тромбоцитыа) Структура
| 1) Это безъядерные фрагменты цитоплазмы (1), отделившиеся в красном костном мозгу от мегакариоцитов и циркулирующие в крови. 2) Центральная область тромбоцита – грануломер с органеллами и гранулами, содержащими ряд факторов свёртывания крови, серотонин, ионы Са2+ и др. 3) Периферическая область – гиаломер: содержит цитоскелет (микротрубочки, микрофиламенты) и канальцы. |
Рис. 8.7.
Тромбоциты
Рис. 8.7.
Тромбоциты
|
б) Функция
| Тромбоциты участвуют в свёртывании крови. С их помощью происходит : 1) образование «белого» тромба – из слипшихся тромбоцитов, 2) сужение сосудов – с помощью содержимого гранул – серотонина и тромбоксанов, 3) ускорение реакций образования «красного» тромба – благодаря связыванию факторов свертывания крови с поверхностью тромбоцитов, 4) уплотнение сгустка крови – за счёт фермента трансглутаминазы (фактор XIII), высвобождающегося из гранул тромбоцитов и образующего в сгустке поперечные связи. |
Тема 9. Собственно соединительные ткани.
Соединительные ткани со специальными свойствами
Дата добавления: 2015-08-04; просмотров: 978;
